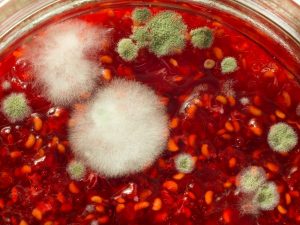

【監修者:管理栄養士 坂本圭子】
朝食のトーストに塗ろうとジャムの瓶を開けたところ、白と緑のカビが生えていました。
中身もたくさん残っていますし、なんといっても賞味期限はまだまだ先!食べられるなら食べたいところです…。
「表面のカビだけ取り除くと食べられるかな?」「黒いカビはダメだけど、白いカビなら大丈夫…なんてことはあるかな?」と、かすかな望みをかけて、ジャムのカビについて調べてみました。以下のようにまとめてご紹介します!
- 白・黒・緑など、ジャムのカビの種類や見分け方
- カビが生えたジャムは食べられるのか
- 食べるとどうなるのかと、食べた後の対処法
- ジャムにカビが生える原因とは
- カビ防止の方法と長持ちさせる正しい保存方法
賞味期限までは十分な期間があるのに、カビが生えてしまったことに少しばかり不満も感じ、カビが生える原因についても調べました。
原因がわかれば、それを元にカビさせずに長持ちさせられる正しい保存方法もわかりますよね。
「ジャムは時々しか使わない」「うっかりしていたらカビが!」なんて、私のような経験をお持ちの方はきっと多いはず!
この記事をお読みいただいて、カビを生やさず最後までジャムを食べきれるようになりましょう♪
記事監修・坂本圭子先生管理栄養士・栄養士
目次
ジャムの危険なカビの見分け方は?白・黒・緑など、見た目や種類を解説!
今回私がカビさせてしまったのはラズベリーですが、ジャムにはいろんな種類がありますよね。

いちごやブルーベリーなどのベリー系、柑橘系の皮が入ったマーマレード、ピーナッツバターや、ココナッツを使って作られるカヤジャムなど…味や見た目も様々です。
残念ながら、どんなジャム類にもカビが生える可能性はあります。
では、どんな種類のカビがあるのでしょうか?危険性の見分け方はあるのでしょうか?
まずはどのようなカビがあるのか、画像をご紹介しますね。
よく見られるのは白いカビで、フワフワと白い綿のようなものが表面の一部分に付いていることが多いです。

白カビと言えば、カマンベールチーズも白カビチーズですし、日常的に見かけることが多いカビではないでしょうか。
もう少し怖い見た目になると、青や緑っぽいカビがあります。

我が家のジャムは、ジャムの赤・フワフワの白いカビ・緑のカビ…と、見事なコントラストでした…。
緑のカビも、上だけに浮いたような状態で生えていることが多く、何となく取り除いたら食べられるのではと思ってしまいます。
もっとグロテスクになると、黒カビや赤カビが生えることもあります。

ひゃーーー!!!
こうなるとどう考えても食べられないとわかりますし、間違っても食べようとは思いませんね。
なかったことにして封印してしまいたい気持ちです…。
これら白・緑・黒などのカビは自然界に普通に存在しているもので、中には私たちの生活に必要なものもあります。
例えば先ほども少しご紹介したように、白カビがカマンベールチーズの、青カビがゴルゴンゾーラの製造に使われていますよね。

さらに青カビの中には、世界初の抗生物質「ペニシリン」が含まれるものまであります!

このように、すべてが体に有害なわけではありません。
ただ、カビには大変多くの種類があり、無害なものもあれば非常に強い毒性を持つ種類もあります。
よく似た見た目でも種類が違う場合もあり、「白いカビならOK!黒いカビならNG!」などと簡単に判断できません。
私たちはカビのプロではないので、見た目で判断できない以上、カビが無害なのか有害なのか見極められませんね。
強い毒性を持っているカビだったら大変です!カビは食べないように注意しましょう。
また、処分の方法にも注意が必要ですので、後ほどご紹介する「正しい処分方法」を参考になさってくださいね。
カビが見えなくても危険な場合も。こんな時は注意!
カビを目で確認できれば危険だとわかりやすいですよね。
でも、カビが生えていなくても危険な場合もあるんです!次のような時には注意してください。
- カビ臭い・シンナー臭など、異様なにおいがある
- 全体的に水っぽくなっている
白や緑のカビは見えないけれど、瓶を開けた時にカビ臭いにおいがする場合、見えないカビが発生していて「これからどんどん増えますよ~」という状態の可能性があります。
カビ臭い以外にも、シンナー臭のような鼻をつくにおいがすることもあるようです。
これは、菌の一種である酵母の増殖が原因だと考えられます。酵母が増えて発酵が進むと、シンナー臭の元となる酢酸エチルという成分が発生するのです。

あくまで発酵の段階で腐敗とまではいかなくても、変質している可能性が考えられますので、蓋を開けてにおいに違和感を感じる場合も、食べないほうが賢明でしょう。
また、ジャム全体が水っぽくなっている場合も、増殖した酵母がジャムのとろみ成分である「ペクチン」を分解していると考えられます。
刺激臭がする場合と同様、発酵しているサインですので、食べないほうが良いでしょう。
ただ、全体ではなく使いかけのジャムの上部のみが水っぽい時は、混ぜた時に一部が分離しているだけなので、品質に問題はありません。ご安心くださいね。
ブルーベリー系のジャムの白い点は、カビじゃない可能性がある!その正体は?
表面にカビの生えたジャムについて解説してきましたが、ブルーベリージャムの表面が白くなっている場合、カビではない可能性があります。
ブルーベリーやぶどうなどの果物は、皮の表面が白い粉のようなロウ質のもので覆われている場合があります。
これは果紛やブルームと呼ばれ、表面を保護するために果実自身が分泌するものです。

体に悪いものではなく、むしろブルームは、果実が収穫されてから日が経っていない、新鮮さの証拠なのですよ♪
ブルームが付いた果実でジャムを作った場合、ジャムの表面に現れることがあります。
とは言え、「なるほどー!じゃあブルーベリージャムの表面が白くても、大丈夫だね!」…と、簡単に思い込めるものではありません。
こちらの方も悩んでおられます。
買ったばかりのナツハゼ ジャム
開けたらこんな感じなんだけど…
これはカビではないのかな…?
ブルーム?誰か教えて下さい! pic.twitter.com/fsUWUEd5GG
— kaori (@chikubanF) November 6, 2018
残念ながら私には、この写真の白っぽいものがブルームかどうかはわからないのですが、見分け方のポイントをご紹介したいと思います。
- ブルームの場合白い結晶のように見える
- フワフワした白い綿状の場合、カビだと考えられる
- 初めて開栓した市販ジャムの表面が白い場合、ブルームの可能性が高い
フワフワした見た目の場合はカビと考えてくださいね。
通常市販のジャムは、雑菌やカビが入り込まないように処理して密閉されていますので、密閉が保たれた状態でカビが生えることはほとんど考えられません。
初めて蓋を開けて「ポン」と空気の音がしたのに、表面が白い…といった場合は、おそらくカビではなくブルームです!
もしどうしても不安な場合は、メーカーに問い合わせてみられてはいかがでしょうか。

ジャムには様々な種類のカビが生えること、カビは食べないほうが良いことがわかりました。
では、カビの部分さえ取り除けば食べられるのでしょうか?また、うっかりカビを食べてしまったらどうなるのでしょうか?
次の章で詳しく解説しますので、健康のためにもぜひしっかりご確認いただきたいです♪
ジャムのカビは取り除くと対処できる?間違って食べたらどうなるかも調査
カビには強い毒性を持つ種類もあり、見極められない以上食べないほうが良いことがわかりましたね。
では、カビそのものを取り除くと残りのジャムは食べられるのでしょうか?
もしくは加熱処理などの対処法はあるのでしょうか?

残念ながら、カビを取り除いても、たとえ再加熱したとしても安心できません!その理由は次の通りです。
カビを取り除いても安心できない理由
- ジャムの中に見えない菌糸が残っている可能性がある
- 見えないカビの胞子が残っている可能性がある
- 熱に強い種類のカビも存在する
- カビが死滅しても、発したカビ毒を取り除くのは難しい
カビは菌糸という根のようなものをのばしますが、菌糸は目に見えません。カビの周りを多めに取り除いても残っているかもしれませんね。
同じく目に見えないものに、胞子やカビ毒があります。
胞子はカビの種のようなもので、やはり体に悪影響を及ぼす可能性があります。カビに対してアレルギーを持ってると、アレルギー反応を引き起こす恐れもありますよ!

カビの中には強い耐熱性を持つ種類もありますし、たとえカビそのものが死滅しても、発生したカビ毒は熱に強くて残ってしまった…なんてことも…。
一度カビが生えたジャムを完璧に無害化する対処法はありませんので、残念ですが諦めるほうが良さそうですね。
やはり最後まで食べきるためにはカビさせないようにしなければ…そのコツについては、後ほど「ジャムのカビ防止対策は?長持ちする保存方法や日持ち期間も紹介」の章で詳しく解説しますよ♪
カビを食べたらどうなる?症状や対処法をご紹介!
全体にフサフサのカビが生えていたら間違って食べることもないと思いますが、少し食べてからジャムの表面に小さな白いカビを発見…なんてことはあるかもしれません。

カビを食べたらどうなってしまうのでしょうか?
調べてみると、少量のカビを食べたからと言って、すぐに大きな健康被害が起こるとは限らないことがわかりました。
少し安心しますね♪
少量なら大丈夫…と言えるのは、胃酸がカビを退治してくれるからです!
これは、赤ちゃんや子供、妊娠中の妊婦さんでも同じことですよ。
特に赤ちゃんは「変な味がするよ」などと教えてくれないので心配ですが、カビを少し口にしたかもしれない…と言って病院に駆け込む必要はありません。

体調に変化がないかどうか、しばらく様子を見てくださいね。

また、カビの生えた食品を食べた後に体調不良が起こる場合、その原因はカビではないかもしれません。
食品にカビが生える…という事は、外から菌が入り込んでいたり、保存期間が長くなっている可能性が高いですよね。
そんな状態の食品には、食中毒菌が発生している可能性もあるのです。赤ちゃんや免疫力が落ちている妊婦さんは特に注意が必要です!
食中毒の主な症状は腹痛・下痢・嘔吐・発熱などで、続くと脱水症状を引き起こして危険な場合もあります。

何度も嘔吐下痢が続いたり、ぐったりした様子が見られる時には病院で診察を受けてくださいね。
カビが生えたジャムはどうやって捨てる?正しい処分方法とは?
カビが生えたジャムは捨てるしかありません…とご説明しましたが、果たしてどのように捨てれば良いのでしょうか?
そのまま中身をゴミ箱にボトボト捨てたり、排水口に流したりするのは危険です!
カビの胞子を豪快にまき散らすことになるからです!

以下になるべく危険の少ない捨て方をご紹介しますので、参考になさってくださいね。
カビの生えたジャムの捨て方
- 瓶の蓋を静かに開ける
- 瓶の中にキッチンハイターなどの塩素系漂白剤を入れる
- 蓋をしっかり閉めて少し振る
- 5分~10分程放置してカビを死滅させ、中身をビニール袋に入れて捨てる
瓶から取り出す前に、カビを死滅させることが大切です!
その後に食べるわけでは無いので、キッチンハイターやカビキラーで退治できちゃいますね。
また、ジャムのような粘りのあるものを排水口に流すと、詰まりの原因にもなりますし、水質の汚染にもつながります。
健康を守るためにも、自然を守るためにも、正しい方法で処分しましょうね。
カビが生えたジャムを食べたらどうなるのかや、処分方法もわかりましたが、いったいなぜ我が家のジャムはカビてしまったのでしょうか?
私のように「まだ開けてから日が浅いのに…」と不満を覚えている方の為にも、続いてはジャムにカビが生える原因を解説します。
これをお読みいただけば、「悲しいけれど、なるほどな…」とご納得いただけると思いますよ!
ジャムにカビが生える原因は?未開封より開封後の方がカビやすい理由
何度も書きますが、お恥ずかしながら私はジャムをカビさせてしまいました。
ところが調べてみると、本来ジャムはカビが生えにくい、腐りにくい食材だとわかりました!

食品を腐らせるカビや細菌が繁殖するためには、空気・栄養・水分が必要です。
ところがジャムのように糖度が高い食品の中では、浸透圧によって砂糖が食品中の水分を吸い取って離さず、水分不足でカビや細菌が増殖できない…と言うのが腐りにくい理由です。
それにもかかわらず腐ってしまうのはなぜでしょうか?
考えられる原因を次にまとめますね!
ジャムが腐る原因
- 糖度が低い
- 水分量が多い
- 開封時に外部からカビや細菌が入り込んだ
- 保存環境が悪い
「糖度が高くて腐りにくい」ジャムですが、糖度が「どのくらい高いのか」が腐りにくさに大きく影響します。賞味期限の設定にも関係しているんですよ!
| 糖度 | 呼び方 | 賞味期限の目安(瓶詰の場合) |
| 糖度65%以上 | 高糖度 | 2年以内 |
| 糖度55%以上65%未満 | 中糖度 | |
| 糖度40%以上55%未満 | 低糖度 | 18ヶ月以内 |
糖度が高いほど賞味期限の目安が長く、より腐りにくいことがわかりますね。ジャムに限らず糖度65%を超える食品はほとんど腐らないとさえ言われています。
しかし最近は健康志向が強くなっている影響もあり、糖度が低いジャムも多くなっています。
↓アヲハタ55ジャム (糖度42%:賞味期限12ヶ月)
ジャムと言えばアヲハタのイメージが強いですが、アヲハタ55ジャムは実は低糖度ジャムだったのですね!
このような低糖度のジャムは腐る確率が高くなりますので、注意が必要です。
そうは言っても市販のジャムの場合、滅菌処理してから密閉されていますので、未開封の状態でカビが生えるとは考えにくいでしょう。
一方で、開封後は空気中の雑菌やカビの胞子が入り込む可能性がありますし、ジャムをすくうために使ったスプーンに菌や水分が付着している場合もあります。
また、使った後の保存方法にも注意が必要で、高温多湿などカビが繁殖しやすい環境に置いていると腐りやすくなります。
手作りジャムは市販ジャムと比べてカビが生えやすい?原因は?
ここまで市販ジャムにカビが生える原因について解説してきましたが、ジャムを手作りする方もいらっしゃることでしょう。
実は私も、春にはジューンベリーと言う庭木の実を摘んでジャムにします。

手作りの場合は、さらに次のような事柄がジャムのカビの原因となり得ます。
手作りジャム特有の、カビる原因
- 保存料が入っていないので単純に腐りやすい
- 保存容器(瓶など)が清潔でない
- 密閉できておらず、開封前にカビが発生する
手作りの場合、ジャムを詰める調理器具や保存容器の消毒を怠ると、雑菌が入り込んでカビの原因となってしまいます。
また、完全に密閉できず、保存中に菌を含む空気が入り込んだり、ジャムを容器に詰める際に、容器内に菌を含む空気が残っている場合もあります。

こうなると、「まだ一度も開けていないから大丈夫!」と思っていても、開栓したら中にカビがびっしり…なんて悲しい結末を迎えることになりかねません。
そうならない為に、手作りジャムを詰める際のおすすめの方法をご紹介しますね♪
- 保存容器(瓶がおすすめ)は蓋も一緒に煮沸消毒する
- ジャムが熱いうちに、消毒した容器の90〜95%程度まで詰める
- 緩めに蓋をして容器が半分以上浸かる程度のお湯で煮沸する(20~30分程)
- 取り出してきつく蓋を閉める
市販ジャムの保存には失敗しましたが、手作りジャムの詰め方は知っているんです(笑)
熱いジャムを詰めた容器を煮沸することを「脱気」と呼び、脱気に成功すれば容器中の空気が抜けますので、菌が酸欠状態で増えにくくなります。
また、これからジャムを手作りされる方は、器具や容器の煮沸はくれぐれもお忘れなく…!

さて、カビが生える原因が分かったので、最後にカビを防止してジャムを長持ちさせられる正しい保存方法についてご紹介します。
これを知っておけば、今後ジャムの保存方法で困ることはなくなるはずですよ。最後までお付き合いくださいね♪
ジャムのカビ防止対策は?長持ちする保存方法や日持ち期間も紹介
ジャムをカビさせないためにはどうすれば良いのでしょうか?
これまでにわかったカビが生える原因も参考に考えると、カビ防止のためには次のような対策が効果的でしょう!
- 蓋を開けっ放しにせず、その都度すぐに閉める
- 開封後はなるべく早く食べきる
- 開封後は冷蔵庫で保存する
- 清潔なスプーンを使う
外からの雑菌の侵入をなるべく少なくするためには、蓋を開けている時間はなるべく短くし、清潔で乾いたスプーンを使うことも大切です。
特に、ジャムをすくったスプーンを舐めると、口の中の雑菌や水分が大量に付着するので、それをそのまま繰り返し使ったりするのは非常に危険です。

子どもにジャムを自由に塗らせてやりたい時などは、あらかじめ使う分だけ取り分けておくと良いですね♪
また仮に、保存方法に「直射日光を避けた常温で保存」と記載されているジャムであっても、開封後は必ず冷蔵庫で保存しましょう!常温ではカビが繁殖しやすくなってしまいます。
そして、冷蔵保存したものを使う際は、長く常温に置かないことも大切です。冷蔵→常温と温度が上がると、結露が発生するからです。
ジャムの瓶の内側が結露すると、その水分がカビの原因となってしまいますよね。
開封後の日持ち期間はどれくらい?長期保存のために冷凍できる?
我が家のカビジャムをみて、「賞味期限はまだまだ先なのに…」と少し不服に思っていた私ですが、そもそも賞味期限とは「未開封で正しく保存した場合においしく食べられる期間」を示したものだとわかりました。

ジャムに限らず、開封後に賞味期限をアテにすること自体が間違っているわけですね。
それなら開封後のジャムはどのくらい日持ちするのか…と調べたところ、アヲハタでは「開栓後の保存目安は2週間」と明言されていました!
もちろん、雑菌やカビがどれくらい入り込んでいるかや保存環境によって前後はありますが、ある程度の目安にできそうです。
でも、毎日ジャムを使うわけで無ければ、2週間で使い切れるかどうか怪しいところではないでしょうか。私の印象としても「結構短い!」と言うのが本音です。
そんな時は冷凍保存がおすすめです♪
ジャムは糖度が高く、冷凍してもカチコチにはならないので瓶のままでの保存も可能です。

ただし、いっぱいいっぱいにジャムが入った瓶を冷凍すると、中身の体積が増えて瓶が割れる恐れがありますので、容器を入れ替えるほうが良いでしょう。
冷凍する場合の便利な保存方法は、ラップで1回分ずつ小分けにし、ジップロックなどの密閉袋に入れる方法です。
小分けにしておけば、使う時に雑菌が侵入するリスクがなくなりますし、ラップと密閉袋の2重にすることで冷凍庫のにおい移りも防げます!
一石二鳥ですね♪
冷凍すれば1ヶ月程の日持ちを見込めますので、冷蔵庫より長期間の保存が可能になりますよ。
まとめ
ジャムに生えたカビが食べられるかどうかの見分け方や危険性と、カビさせず長持ちさせる正しい保存方法などについて解説してきました!
- ジャムに生えるカビの中には無害なものも有害なものもある
- カビの種類や危険性を見分けることは困難
- カビを取り除いても菌糸や胞子が残っていたり、食中毒菌が発生している可能性がある
- カビが生えたジャムは食べないほうが良い
- カビを少し食べてもすぐに体調不良が起こるとは限らない
- 捨てる際はハイターでカビを死滅させてから、袋に入れてゴミに出す
- 嘔吐・下痢など強い食中毒症状が出た場合は医療機関を受診する
- カビや菌の侵入を防ぐため、清潔なスプーンを使って取り、すぐに蓋を閉める
- 開封後は冷蔵庫や冷凍庫で保存する(日持ちや方法は以下の通り)
| 保存場所 | 日持ち目安 | 保存方法・注意事項 |
| 冷蔵庫 | 約2週間 | 結露に注意する |
| 冷凍庫 | 約1ヶ月 | ・瓶のままでも良いが、割れる恐れがある ・ラップで小分けにし、密閉袋に入れる |
我が家では、スプーンを瓶に入れっぱなしにして家族で使いまわしするので、それがいけなかったのだろうと反省しています。

危険なカビとそうでないカビを見分けることも、無害化することも不可能なので、発見したカビジャムはハイターを使って正しく処分しようと思います。
そしてこれからは、その時に使いそうな量をお皿に取り分けて使います!
少しの注意と手間で日持ちを長くできることもわかったことですし、みなさんも正しい保存方法で最後までおいしくジャムを使いきってくださいね♪


